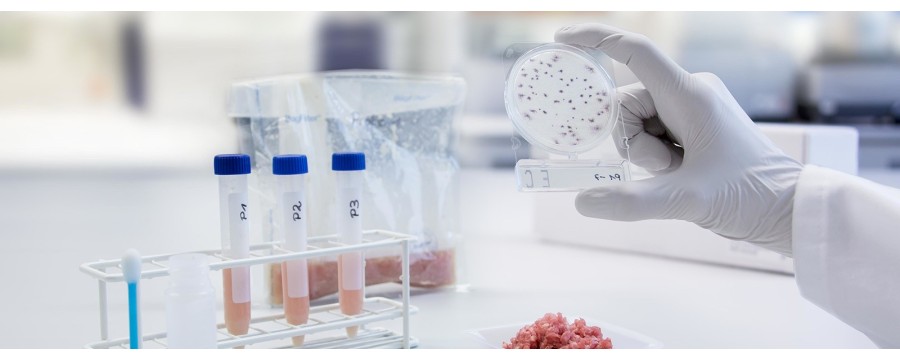
Culture cellulaire

Culture cellulaire
Retrouvez l'équipement de culture cellulaire : matériel, logiciel de numération de cellules et solutions de surveillance pour rationaliser vos processus.
Il y a 5 produits.
Les pointes PIPETMAN® DIAMOND sont conçues pour s’adapter parfaitement à votre PIPETMAN
PIPETMAN DIAMOND Tips DF200ST TIPACK
Les pointes PIPETMAN® DIAMOND sont conçues pour sadapter parfaitement à votre PIPETMAN
Nunc™ MicroWell™ MiniTrays
Boîtes de culture cellulaire






